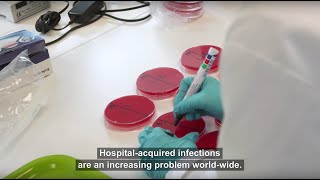

The fight against healthcare associated infections video
Online izle ve mp4 mp3 formatlarinda yukle
Videonun muddeti: 4:57
The fight against healthcare associated infections videosu mp4 ve mp3 yuklemek ucun hazirdir
Diqqet! Siz Mp4 yukle ve ya Mp3 yukle duymesine basdiqdan sonra eger sistem sizi reklam sehifesine atarsa o zaman derhal geri qayidib emeliyyati tekrar edin ve faylin yuklemek ucun hazir olmasini gozleyin
Videodan Mp4 Yukle
Videodan Mp3 Yukle-1
Videodan Mp3 Yukle-2
Oxshar Axtarishlar
The fight against healthcare associated infections
The Fight Against Healthcare Acquired Infections (HAIs)
What are the Main Barriers in the Fight Against HAIs?
Healthcare-Associated Infections in the United States
How Does the CDC Aid State Health Departments in the Fight Against HAIs?
Patient safety first! Assessing healthcare-associated infections in European hospitals
New Tools in the Battle Against Hospital-Acquired Infections*
Health care-associated infections – an overview – Video abstract [ID 177247]
UTIs & CAUTIs Explained | Candida Infections in Hospitals & ICU | Fungal UTI Treatment & Resistance
Video Mp4 Mp3Azwap.Biz
Azwap.Biz 2021-2023